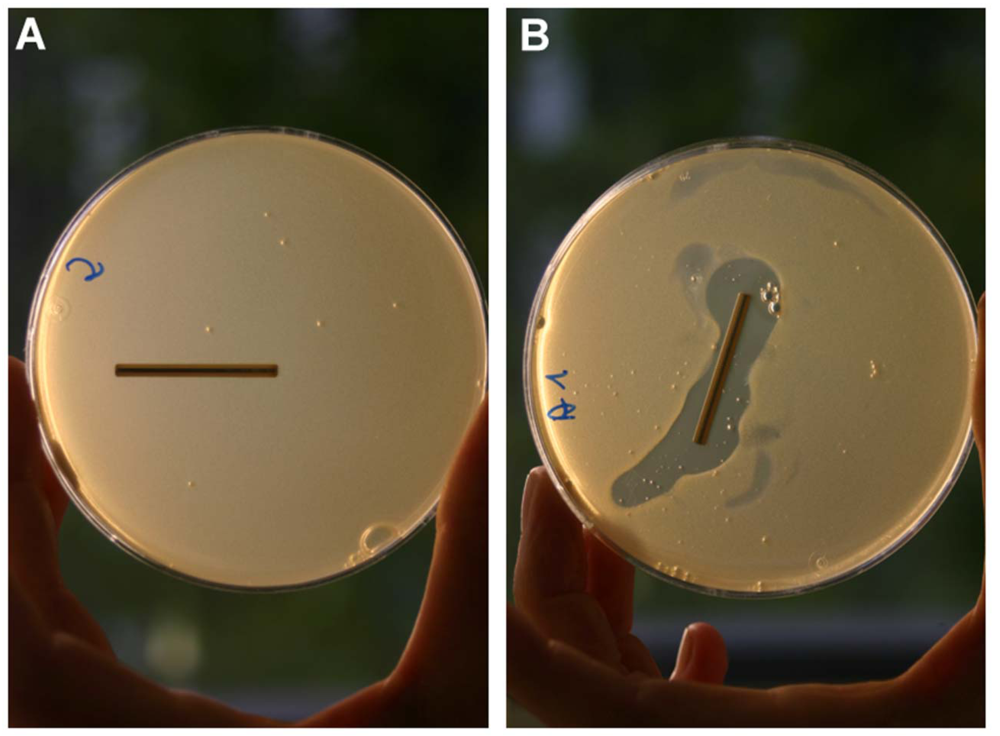
Polymers 04 00539 g003

Antimicrobial Peptides: Multifunctional Drugs for Different Applications
Abstract
:1. Introduction
| Family Class Human example Localization References |
|---|
| Defensins α-defensin HNP-1-4, Neutrophils, NK cells [30] |
| HD-5, HD-6 Paneth cells |
| β-defensin HBD-1-4 widely distributed [31] |
| leukocytes and |
| epithelial cells, |
| for example: tongue, |
| skin, cornea, salivary glands, |
| kidneys, esophagus |
| and respiratory tract |
| θ-defensin not determined in leukocytes of primates [32] |
| Cathelicidins LL-37 widely distributed [33] |
| leukocytes and |
| epithelial cells, |
| for example: |
| epithelia of skin, gut |
| and lungs |
| and brain tissue |
| Histatins HIS-1, 3 or 5 saliva, submandibular [34] |
| sublingual and |
| parotid glands |
2. Diversity of Functions
2.1. Antimicrobial Activity

2.2. Immunomodulatory and Further Activities

3. Practical Applications
4. Conclusions and Future Perspectives
Acknowledgments
References
- Zasloff, M. Magainins, a class of antimicrobial peptides from xenopus skin: Isolation, characterization of two active forms, and partial cdna sequence of a precursor. Proc. Natl. Acad. Sci. USA 1987, 84, 5449–5453. [Google Scholar] [CrossRef]
- Zasloff, M.; Martin, B.; Chen, H.C. Antimicrobial activity of synthetic magainin peptides and several analogues. Proc. Natl. Acad. Sci. USA 1988, 85, 910–913. [Google Scholar]
- Bulet, P.; Stocklin, R.; Menin, L. Anti-microbial peptides: From invertebrates to vertebrates. Immunol. Rev. 2004, 198, 169–184. [Google Scholar] [CrossRef]
- Kasahara, M.; Suzuki, T.; Pasquier, L.D. On the origins of the adaptive immune system: Novel insights from invertebrates and cold-blooded vertebrates. Trends Immunol. 2004, 25, 105–111. [Google Scholar] [CrossRef]
- Stotz, H.U.; Thomson, J.G.; Wang, Y. Plant defensins: Defense, development and application. Plant Signal. Behav. 2009, 4, 1010–1012. [Google Scholar] [CrossRef]
- Zasloff, M. Antimicrobial peptides of multicellular organisms. Nature 2002, 415, 389–395. [Google Scholar] [CrossRef]
- Varoga, D.; Pufe, T.; Mentlein, R.; Kohrs, S.; Grohmann, S.; Tillmann, B.; Hassenpflug, J.; Paulsen, F. Expression and regulation of antimicrobial peptides in articular joints. Ann. Anat. 2005, 187, 499–508. [Google Scholar] [CrossRef]
- Schroder, J.M. The role of keratinocytes in defense against infection. Curr. Opin. Infect. Dis. 2010, 23, 106–110. [Google Scholar] [CrossRef]
- Bergman, P.; Johansson, L.; Wan, H.; Jones, A.; Gallo, R.L.; Gudmundsson, G.H.; Hokfelt, T.; Jonsson, A.B.; Agerberth, B. Induction of the antimicrobial peptide cramp in the blood-brain barrier and meninges after meningococcal infection. Infect. Immun. 2006, 74, 6982–6991. [Google Scholar] [CrossRef]
- Brandenburg, L.O.; Varoga, D.; Nicolaeva, N.; Leib, S.L.; Podschun, R.; Wruck, C.J.; Wilms, H.; Lucius, R.; Pufe, T. Expression and regulation of antimicrobial peptide rcramp after bacterial infection in primary rat meningeal cells. J. Neuroimmunol. 2009, 217, 55–64. [Google Scholar] [CrossRef]
- Zaiou, M. Multifunctional antimicrobial peptides: Therapeutic targets in several human diseases. J. Mol. Med. 2007, 85, 317–329. [Google Scholar] [CrossRef]
- De Smet, K.; Contreras, R. Human antimicrobial peptides: Defensins, cathelicidins and histatins. Biotechnol. Lett. 2005, 27, 1337–1347. [Google Scholar] [CrossRef]
- Wang, G.; Li, X.; Wang, Z. APD2: the updated antimicrobial peptide database and its application in peptide design. Nucleic Acids Res 2009, 37, D933–D937. [Google Scholar]
- Ganz, T. Defensins: Antimicrobial peptides of innate immunity. Nat. Rev. Immunol. 2003, 3, 710–720. [Google Scholar] [CrossRef]
- Zanetti, M. The role of cathelicidins in the innate host defenses of mammals. Curr. Issues Mol. Biol. 2005, 7, 179–196. [Google Scholar]
- Gudmundsson, G.H.; Agerberth, B.; Odeberg, J.; Bergman, T.; Olsson, B.; Salcedo, R. The human gene fall39 and processing of the cathelin precursor to the antibacterial peptide ll-37 in granulocytes. Eur. J. Biochem. 1996, 238, 325–332. [Google Scholar]
- Frohm, M.; Agerberth, B.; Ahangari, G.; Stahle-Backdahl, M.; Liden, S.; Wigzell, H.; Gudmundsson, G.H. The expression of the gene coding for the antibacterial peptide ll-37 is induced in human keratinocytes during inflammatory disorders. J. Biol. Chem. 1997, 272, 15258–15263. [Google Scholar]
- Nizet, V.; Ohtake, T.; Lauth, X.; Trowbridge, J.; Rudisill, J.; Dorschner, R.A.; Pestonjamasp, V.; Piraino, J.; Huttner, K.; Gallo, R.L. Innate antimicrobial peptide protects the skin from invasive bacterial infection. Nature 2001, 414, 454–457. [Google Scholar]
- Bergman, P.; Termen, S.; Johansson, L.; Nystrom, L.; Arenas, E.; Jonsson, A.B.; Hokfelt, T.; Gudmundsson, G.H.; Agerberth, B. The antimicrobial peptide rcramp is present in the central nervous system of the rat. J. Neurochem. 2005, 93, 1132–1140. [Google Scholar] [CrossRef]
- Brandenburg, L.O.; Varoga, D.; Nicolaeva, N.; Leib, S.L.; Wilms, H.; Podschun, R.; Wruck, C.J.; Schroder, J.M.; Pufe, T.; Lucius, R. Role of glial cells in the functional expression of ll-37/rat cathelin-related antimicrobial peptide in meningitis. J. Neuropathol. Exp. Neurol. 2008, 67, 1041–1054. [Google Scholar] [CrossRef]
- Larrick, J.W.; Hirata, M.; Balint, R.F.; Lee, J.; Zhong, J.; Wright, S.C. Human cap18: A novel antimicrobial lipopolysaccharide-binding protein. Infect. Immun. 1995, 63, 1291–1297. [Google Scholar]
- Huttner, K.M.; Bevins, C.L. Antimicrobial peptides as mediators of epithelial host defense. Pediatr. Res. 1999, 45, 785–794. [Google Scholar] [CrossRef]
- Nizet, V.; Gallo, R.L. Cathelicidins and innate defense against invasive bacterial infection. Scand. J. Infect. Dis. 2003, 35, 670–676. [Google Scholar] [CrossRef]
- McGwire, B.S.; Olson, C.L.; Tack, B.F.; Engman, D.M. Killing of african trypanosomes by antimicrobial peptides. J. Infect. Dis. 2003, 188, 146–152. [Google Scholar] [CrossRef]
- Tarasov, V.A.; Khadeeva, N.V.; Mel’nik, V.A.; Ezhova, T.A.; Shestakov, S.V. The atlg12860 gene of arabidopsis thaliana determines cathelicidin-like antimicrobial activity. Dokl. Biol. Sci. 2009, 427, 332–334. [Google Scholar] [CrossRef]
- Ahmad, M.; Piludu, M.; Oppenheim, F.G.; Helmerhorst, E.J.; Hand, A.R. Immunocytochemical localization of histatins in human salivary glands. J. Histochem. Cytochem. 2004, 52, 361–370. [Google Scholar] [CrossRef]
- Padovan, L.; Segat, L.; Pontillo, A.; Antcheva, N.; Tossi, A.; Crovella, S. Histatins in non-human primates: Gene variations and functional effects. Protein Pept. Lett. 2010, 17, 909–918. [Google Scholar] [CrossRef]
- Froy, O. Regulation of mammalian defensin expression by toll-like receptor-dependent and independent signalling pathways. Cell Microbiol. 2005, 7, 1387–1397. [Google Scholar] [CrossRef]
- Braun, B.J.; Slowik, A.; Leib, S.L.; Lucius, R.; Varoga, D.; Wruck, C.J.; Jansen, S.; Podschun, R.; Pufe, T.; Brandenburg, L.O. The formyl peptide receptor like-1 and scavenger receptor marco are involved in glial cell activation in bacterial meningitis. J. Neuroinflammation 2011, 8, 11–15. [Google Scholar] [CrossRef] [Green Version]
- Lehrer, R.I.; Lu, W. Alpha-defensins in human innate immunity. Immunol. Rev. 2012, 245, 84–112. [Google Scholar] [CrossRef]
- Pazgier, M.; Li, X.; Lu, W.; Lubkowski, J. Human defensins: Synthesis and structural properties. Curr. Pharm. Des. 2007, 13, 3096–3118. [Google Scholar]
- Tongaonkar, P.; Tran, P.; Roberts, K.; Schaal, J.; Osapay, G.; Tran, D.; Ouellette, A.J.; Selsted, M.E. Rhesus macaque theta-defensin isoforms: Expression, antimicrobial activities, and demonstration of a prominent role in neutrophil granule microbicidal activities. J. Leukoc. Biol. 2011, 89, 283–290. [Google Scholar] [CrossRef]
- Bucki, R.; Leszczynska, K.; Namiot, A.; Sokolowski, W. Cathelicidin ll-37: A multitask antimicrobial peptide. Arch. Immunol. Ther. Exp. (Warsz.) 2010, 58, 15–25. [Google Scholar] [CrossRef]
- Wiesner, J.; Vilcinskas, A. Antimicrobial peptides: The ancient arm of the human immune system. Virulence 2010, 1, 440–464. [Google Scholar] [CrossRef]
- Diamond, G.; Beckloff, N.; Weinberg, A.; Kisich, K.O. The roles of antimicrobial peptides in innate host defense. Curr. Pharm. Des. 2009, 15, 2377–2392. [Google Scholar] [CrossRef]
- Mihajlovic, M.; Lazaridis, T. Antimicrobial peptides in toroidal and cylindrical pores. Biochim. Biophys. Acta 2010, 1798, 1485–1493. [Google Scholar] [CrossRef]
- Giuliani, A.; Pirri, G.; Bozzi, A.; Di Giulio, A.; Aschi, M.; Rinaldi, A.C. Antimicrobial peptides: Natural templates for synthetic membrane-active compounds. Cell Mol. Life Sci. 2008, 65, 2450–2460. [Google Scholar] [CrossRef]
- Matsuzaki, K. Why and how are peptide-lipid interactions utilized for self-defense? Magainins and tachyplesins as archetypes. Biochim. Biophys. Acta 1999, 1462, 1–10. [Google Scholar] [CrossRef]
- Yeaman, M.R.; Yount, N.Y. Mechanisms of antimicrobial peptide action and resistance. Pharmacol. Rev. 2003, 55, 27–55. [Google Scholar] [CrossRef]
- Yeung, A.T.; Gellatly, S.L.; Hancock, R.E. Multifunctional cationic host defense peptides and their clinical applications. Cell Mol. Life Sci. 2011, 68, 2161–2176. [Google Scholar]
- Welling, M.M.; Lupetti, A.; Balter, H.S.; Lanzzeri, S.; Souto, B.; Rey, A.M.; Savio, E.O.; Paulusma-Annema, A.; Pauwels, E.K.; Nibbering, P.H. 99mtc-labeled antimicrobial peptides for detection of bacterial and candida albicans infections. J. Nucl. Med. 2001, 42, 788–794. [Google Scholar]
- Johansson, J.; Gudmundsson, G.H.; Rottenberg, M.E.; Berndt, K.D.; Agerberth, B. Conformation-dependent antibacterial activity of the naturally occurring human peptide ll-37. J. Biol. Chem. 1998, 273, 3718–3724. [Google Scholar]
- Wiese, A.; Gutsmann, T.; Seydel, U. Towards antibacterial strategies: Studies on the mechanisms of interaction between antibacterial peptides and model membranes. J. Endotoxin Res. 2003, 9, 67–84. [Google Scholar]
- Warren, H.S.; Matyal, R.; Allaire, J.E.; Yarmush, D.; Loiselle, P.; Hellman, J.; Paton, B.G.; Fink, M.P. Protective efficacy of cap18106-138-immunoglobulin g in sepsis. J. Infect. Dis. 2003, 188, 1382–1393. [Google Scholar] [CrossRef]
- Kai-Larsen, Y.; Agerberth, B. The role of the multifunctional peptide ll-37 in host defense. Front. Biosci. 2008, 13, 3760–3767. [Google Scholar] [CrossRef]
- Brogden, K.A. Antimicrobial peptides: Pore formers or metabolic inhibitors in bacteria? Nat. Rev. Microbiol. 2005, 3, 238–250. [Google Scholar] [CrossRef]
- Murakami, Y.; Xu, T.; Helmerhorst, E.J.; Ori, G.; Troxler, R.F.; Lally, E.T.; Oppenheim, F.G. Inhibitory effect of synthetic histatin 5 on leukotoxin from actinobacillus actinomycetemcomitans. Oral Microbiol. Immunol. 2002, 17, 143–149. [Google Scholar] [CrossRef]
- Gusman, H.; Travis, J.; Helmerhorst, E.J.; Potempa, J.; Troxler, R.F.; Oppenheim, F.G. Salivary histatin 5 is an inhibitor of both host and bacterial enzymes implicated in periodontal disease. Infect. Immun. 2001, 69, 1402–1408. [Google Scholar] [CrossRef]
- Ganz, T.; Metcalf, J.A.; Gallin, J.I.; Boxer, L.A.; Lehrer, R.I. Microbicidal/cytotoxic proteins of neutrophils are deficient in two disorders: Chediak-higashi syndrome and “Specific” Granule deficiency. J. Clin. Invest. 1988, 82, 552–556. [Google Scholar] [CrossRef]
- Putsep, K.; Carlsson, G.; Boman, H.G.; Andersson, M. Deficiency of antibacterial peptides in patients with morbus kostmann: An observation study. Lancet 2002, 360, 1144–1149. [Google Scholar]
- Moser, C.; Weiner, D.J.; Lysenko, E.; Bals, R.; Weiser, J.N.; Wilson, J.M. Beta-defensin 1 contributes to pulmonary innate immunity in mice. Infect. Immun. 2002, 70, 3068–3072. [Google Scholar] [CrossRef]
- Huang, L.C.; Reins, R.Y.; Gallo, R.L.; McDermott, A.M. Cathelicidin-deficient (cnlp -/-) mice show increased susceptibility to pseudomonas aeruginosa keratitis. Invest. Ophthalmol. Vis. Sci. 2007, 48, 4498–4508. [Google Scholar] [CrossRef]
- Zhang, K.; Lu, Q.; Zhang, Q.; Hu, X. Regulation of activities of nk cells and cd4 expression in t cells by human hnp-1, -2, and -3. Biochem. Biophys. Res. Commun. 2004, 323, 437–444. [Google Scholar] [CrossRef]
- Salvatore, M.; Garcia-Sastre, A.; Ruchala, P.; Lehrer, R.I.; Chang, T.; Klotman, M.E. Alpha-defensin inhibits influenza virus replication by cell-mediated mechanism(s). J. Infect. Dis. 2007, 196, 835–843. [Google Scholar] [CrossRef]
- Buck, C.B.; Day, P.M.; Thompson, C.D.; Lubkowski, J.; Lu, W.; Lowy, D.R.; Schiller, J.T. Human alpha-defensins block papillomavirus infection. Proc. Natl. Acad. Sci. USA 2006, 103, 1516–1521. [Google Scholar]
- Daher, K.A.; Selsted, M.E.; Lehrer, R.I. Direct inactivation of viruses by human granulocyte defensins. J. Virol. 1986, 60, 1068–1074. [Google Scholar]
- Bergman, P.; Walter-Jallow, L.; Broliden, K.; Agerberth, B.; Soderlund, J. The antimicrobial peptide ll-37 inhibits hiv-1 replication. Curr. HIV Res. 2007, 5, 410–415. [Google Scholar] [CrossRef]
- Braida, L.; Boniotto, M.; Pontillo, A.; Tovo, P.A.; Amoroso, A.; Crovella, S. A single-nucleotide polymorphism in the human beta-defensin 1 gene is associated with hiv-1 infection in italian children. Aids 2004, 18, 1598–1600. [Google Scholar] [CrossRef]
- Liang, Q.L.; Zhou, K.; He, H.X. Retrocyclin 2: A new therapy against avian influenza h5n1 virus in vivo and vitro. Biotechnol. Lett. 2010, 32, 387–392. [Google Scholar]
- Ryan, L.K.; Dai, J.; Yin, Z.; Megjugorac, N.; Uhlhorn, V.; Yim, S.; Schwartz, K.D.; Abrahams, J.M.; Diamond, G.; Fitzgerald-Bocarsly, P. Modulation of human beta-defensin-1 (hbd-1) in plasmacytoid dendritic cells (pdc), monocytes, and epithelial cells by influenza virus, herpes simplex virus, and sendai virus and its possible role in innate immunity. J. Leukoc. Biol. 2011, 90, 343–356. [Google Scholar] [CrossRef]
- Gallo, S.A.; Wang, W.; Rawat, S.S.; Jung, G.; Waring, A.J.; Cole, A.M.; Lu, H.; Yan, X.; Daly, N.L.; Craik, D.J.; et al. Theta-defensins prevent hiv-1 env-mediated fusion by binding gp41 and blocking 6-helix bundle formation. J. Biol. Chem. 2006, 281, 18787–18792. [Google Scholar]
- Feng, Z.; Dubyak, G.R.; Lederman, M.M.; Weinberg, A. Cutting edge: Human beta defensin 3—A novel antagonist of the hiv-1 coreceptor cxcr4. J. Immunol. 2006, 177, 782–786. [Google Scholar]
- Koo, J.C.; Lee, B.; Young, M.E.; Koo, S.C.; Cooper, J.A.; Baek, D.; Lim, C.O.; Lee, S.Y.; Yun, D.J.; Cho, M.J. Pn-amp1, a plant defense protein, induces actin depolarization in yeasts. Plant Cell Physiol. 2004, 45, 1669–1680. [Google Scholar] [CrossRef]
- De Lucca, A.J.; Walsh, T.J. Antifungal peptides: Novel therapeutic compounds against emerging pathogens. Antimicrob. Agents Chemother. 1999, 43, 1–11. [Google Scholar]
- Jenssen, H.; Hamill, P.; Hancock, R.E. Peptide antimicrobial agents. Clin. Microbiol. Rev. 2006, 19, 491–511. [Google Scholar] [CrossRef]
- Matejuk, A.; Leng, Q.; Begum, M.D.; Woodle, M.C.; Scaria, P.; Chou, S.T.; Mixson, A.J. Peptide-based antifungal therapies against emerging infections. Drugs Future 2010, 35, 197. [Google Scholar]
- Lehrer, R.I.; Ganz, T.; Szklarek, D.; Selsted, M.E. Modulation of the in vitro candidacidal activity of human neutrophil defensins by target cell metabolism and divalent cations. J. Clin. Invest. 1988, 81, 1829–1835. [Google Scholar] [CrossRef]
- Selsted, M.E.; Szklarek, D.; Ganz, T.; Lehrer, R.I. Activity of rabbit leukocyte peptides against candida albicans. Infect. Immun. 1985, 49, 202–206. [Google Scholar]
- Helmerhorst, E.J.; Reijnders, I.M.; van’t Hof, W.; Simoons-Smit, I.; Veerman, E.C.; Amerongen, A.V. Amphotericin b- and fluconazole-resistant candida spp., aspergillus fumigatus, and other newly emerging pathogenic fungi are susceptible to basic antifungal peptides. Antimicrob. Agents Chemother. 1999, 43, 702–704. [Google Scholar]
- Tsai, H.; Bobek, L.A. Human salivary histatin-5 exerts potent fungicidal activity against cryptococcus neoformans. Biochim. Biophys. Acta 1997, 1336, 367–369. [Google Scholar] [CrossRef]
- Benincasa, M.; Scocchi, M.; Pacor, S.; Tossi, A.; Nobili, D.; Basaglia, G.; Busetti, M.; Gennaro, R. Fungicidal activity of five cathelicidin peptides against clinically isolated yeasts. J. Antimicrob. Chemother. 2006, 58, 950–959. [Google Scholar] [CrossRef]
- Lupetti, A.; Danesi, R.; van’t Wout, J.W.; van Dissel, J.T.; Senesi, S.; Nibbering, P.H. Antimicrobial peptides: Therapeutic potential for the treatment of candida infections. Expert Opin. Investig. Drugs 2002, 11, 309–318. [Google Scholar] [CrossRef]
- Huang, C.M.; Chen, H.C.; Zierdt, C.H. Magainin analogs effective against pathogenic protozoa. Antimicrob. Agents Chemother. 1990, 34, 1824–1826. [Google Scholar]
- Haines, L.R.; Thomas, J.M.; Jackson, A.M.; Eyford, B.A.; Razavi, M.; Watson, C.N.; Gowen, B.; Hancock, R.E.; Pearson, T.W. Killing of trypanosomatid parasites by a modified bovine host defense peptide, bmap-18. PLoS Negl. Trop. Dis. 2009, 3. [Google Scholar]
- Park, Y.; Jang, S.H.; Lee, D.G.; Hahm, K.S. Antinematodal effect of antimicrobial peptide, pmap-23, isolated from porcine myeloid against caenorhabditis elegans. J. Pept. Sci. 2004, 10, 304–311. [Google Scholar] [CrossRef]
- Territo, M.C.; Ganz, T.; Selsted, M.E.; Lehrer, R. Monocyte-chemotactic activity of defensins from human neutrophils. J. Clin. Invest. 1989, 84, 2017–2020. [Google Scholar] [CrossRef]
- Auvynet, C.; Rosenstein, Y. Multifunctional host defense peptides: Antimicrobial peptides, the small yet big players in innate and adaptive immunity. FEBS J. 2009, 276, 6497–6508. [Google Scholar] [CrossRef]
- Weidenmaier, C.; Kristian, S.A.; Peschel, A. Bacterial resistance to antimicrobial host defenses—An emerging target for novel antiinfective strategies? Curr. Drug Targets 2003, 4, 643–649. [Google Scholar] [CrossRef]
- Nijnik, A.; Madera, L.; Ma, S.; Waldbrook, M.; Elliott, M.R.; Easton, D.M.; Mayer, M.L.; Mullaly, S.C.; Kindrachuk, J.; Jenssen, H.; et al. Synthetic cationic peptide idr-1002 provides protection against bacterial infections through chemokine induction and enhanced leukocyte recruitment. J. Immunol. 2010, 184, 2539–2550. [Google Scholar]
- Giacometti, A.; Cirioni, O.; Barchiesi, F.; Scalise, G. In vitro activity and killing effect of polycationic peptides on methicillin-resistant staphylococcus aureus and interactions with clinically used antibiotics. Diagn. Microbiol. Infect. Dis. 2000, 38, 115–118. [Google Scholar] [CrossRef]
- Lai, Y.; Gallo, R.L. Amped up immunity: How antimicrobial peptides have multiple roles in immune defense. Trends Immunol. 2009, 30, 131–141. [Google Scholar] [CrossRef]
- Yang, D.; Chertov, O.; Oppenheim, J.J. Participation of mammalian defensins and cathelicidins in anti-microbial immunity: Receptors and activities of human defensins and cathelicidin (ll-37). J. Leukoc. Biol. 2001, 69, 691–697. [Google Scholar]
- Nagaoka, I.; Tamura, H.; Hirata, M. An antimicrobial cathelicidin peptide, human cap18/ll-37, suppresses neutrophil apoptosis via the activation of formyl-peptide receptor-like 1 and p2x7. J. Immunol. 2006, 176, 3044–3052. [Google Scholar]
- Yang, D.; Chertov, O.; Bykovskaia, S.N.; Chen, Q.; Buffo, M.J.; Shogan, J.; Anderson, M.; Schroder, J.M.; Wang, J.M.; Howard, O.M.; et al. Beta-defensins: Linking innate and adaptive immunity through dendritic and t cell ccr6. Science 1999, 286, 525–528. [Google Scholar]
- Chen, X.; Niyonsaba, F.; Ushio, H.; Hara, M.; Yokoi, H.; Matsumoto, K.; Saito, H.; Nagaoka, I.; Ikeda, S.; Okumura, K.; et al. Antimicrobial peptides human beta-defensin (hbd)-3 and hbd-4 activate mast cells and increase skin vascular permeability. Eur. J. Immunol. 2007, 37, 434–444. [Google Scholar] [CrossRef]
- Niyonsaba, F.; Ushio, H.; Nakano, N.; Ng, W.; Sayama, K.; Hashimoto, K.; Nagaoka, I.; Okumura, K.; Ogawa, H. Antimicrobial peptides human beta-defensins stimulate epidermal keratinocyte migration, proliferation and production of proinflammatory cytokines and chemokines. J. Invest. Dermatol. 2007, 127, 594–604. [Google Scholar] [CrossRef]
- Ganguly, D.; Chamilos, G.; Lande, R.; Gregorio, J.; Meller, S.; Facchinetti, V.; Homey, B.; Barrat, F.J.; Zal, T.; Gilliet, M. Self-rna-antimicrobial peptide complexes activate human dendritic cells through tlr7 and tlr8. J. Exp. Med. 2009, 206, 1983–1994. [Google Scholar] [CrossRef]
- Lande, R.; Gregorio, J.; Facchinetti, V.; Chatterjee, B.; Wang, Y.H.; Homey, B.; Cao, W.; Wang, Y.H.; Su, B.; Nestle, F.O.; et al. Plasmacytoid dendritic cells sense self-DNA coupled with antimicrobial peptide. Nature 2007, 449, 564–569. [Google Scholar]
- Dombrowski, Y.; Peric, M.; Koglin, S.; Kammerbauer, C.; Goss, C.; Anz, D.; Simanski, M.; Glaser, R.; Harder, J.; Hornung, V.; et al. Cytosolic DNA triggers inflammasome activation in keratinocytes in psoriatic lesions. Sci. Transl. Med. 2011, 3. [Google Scholar]
- Davidson, D.J.; Currie, A.J.; Reid, G.S.; Bowdish, D.M.; MacDonald, K.L.; Ma, R.C.; Hancock, R.E.; Speert, D.P. The cationic antimicrobial peptide ll-37 modulates dendritic cell differentiation and dendritic cell-induced t cell polarization. J. Immunol. 2004, 172, 1146–1156. [Google Scholar]
- van der Does, A.M.; Beekhuizen, H.; Ravensbergen, B.; Vos, T.; Ottenhoff, T.H.; van Dissel, J.T.; Drijfhout, J.W.; Hiemstra, P.S.; Nibbering, P.H. Ll-37 directs macrophage differentiation toward macrophages with a proinflammatory signature. J. Immunol. 2010, 185, 1442–1449. [Google Scholar]
- Scott, M.G.; Vreugdenhil, A.C.; Buurman, W.A.; Hancock, R.E.; Gold, M.R. Cutting edge: Cationic antimicrobial peptides block the binding of lipopolysaccharide (lps) to lps binding protein. J. Immunol. 2000, 164, 549–553. [Google Scholar]
- Mookherjee, N.; Hancock, R.E. Cationic host defense peptides: Innate immune regulatory peptides as a novel approach for treating infections. Cell Mol. Life Sci. 2007, 64, 922–933. [Google Scholar] [CrossRef]
- Varoga, D.; Pufe, T.; Harder, J.; Schroder, J.M.; Mentlein, R.; Meyer-Hoffert, U.; Goldring, M.B.; Tillmann, B.; Hassenpflug, J.; Paulsen, F. Human beta-defensin 3 mediates tissue remodeling processes in articular cartilage by increasing levels of metalloproteinases and reducing levels of their endogenous inhibitors. Arthritis Rheum. 2005, 52, 1736–1745. [Google Scholar] [CrossRef]
- Howell, M.D.; Novak, N.; Bieber, T.; Pastore, S.; Girolomoni, G.; Boguniewicz, M.; Streib, J.; Wong, C.; Gallo, R.L.; Leung, D.Y. Interleukin-10 downregulates anti-microbial peptide expression in atopic dermatitis. J. Invest. Dermatol. 2005, 125, 738–745. [Google Scholar] [CrossRef]
- Lillard, J.W., Jr.; Boyaka, P.N.; Chertov, O.; Oppenheim, J.J.; McGhee, J.R. Mechanisms for induction of acquired host immunity by neutrophil peptide defensins. Proc. Natl. Acad. Sci. USA 1999, 96, 651–656. [Google Scholar]
- Brogden, K.A.; Heidari, M.; Sacco, R.E.; Palmquist, D.; Guthmiller, J.M.; Johnson, G.K.; Jia, H.P.; Tack, B.F.; McCray, P.B. Defensin-induced adaptive immunity in mice and its potential in preventing periodontal disease. Oral Microbiol. Immunol. 2003, 18, 95–99. [Google Scholar] [CrossRef]
- Mader, J.S.; Ewen, C.; Hancock, R.E.; Bleackley, R.C. The human cathelicidin, ll-37, induces granzyme-mediated apoptosis in regulatory t cells. J. Immunother. 2011, 34, 229–235. [Google Scholar] [CrossRef]
- Sorensen, O.E.; Cowland, J.B.; Theilgaard-Monch, K.; Liu, L.; Ganz, T.; Borregaard, N. Wound healing and expression of antimicrobial peptides/polypeptides in human keratinocytes, a consequence of common growth factors. J. Immunol. 2003, 170, 5583–5589. [Google Scholar]
- Dorschner, R.A.; Pestonjamasp, V.K.; Tamakuwala, S.; Ohtake, T.; Rudisill, J.; Nizet, V.; Agerberth, B.; Gudmundsson, G.H.; Gallo, R.L. Cutaneous injury induces the release of cathelicidin anti-microbial peptides active against group a streptococcus. J. Invest. Dermatol. 2001, 117, 91–97. [Google Scholar] [CrossRef]
- Hirsch, T.; Spielmann, M.; Zuhaili, B.; Fossum, M.; Metzig, M.; Koehler, T.; Steinau, H.U.; Yao, F.; Onderdonk, A.B.; Steinstraesser, L.; et al. Human beta-defensin-3 promotes wound healing in infected diabetic wounds. J. Gene Med. 2009, 11, 220–228. [Google Scholar]
- Koczulla, R.; von Degenfeld, G.; Kupatt, C.; Krotz, F.; Zahler, S.; Gloe, T.; Issbrucker, K.; Unterberger, P.; Zaiou, M.; Lebherz, C.; et al. An angiogenic role for the human peptide antibiotic ll-37/hcap-18. J. Clin. Invest. 2003, 111, 1665–1672. [Google Scholar]
- Brandenburg, L.O.; Jansen, S.; Wruck, C.J.; Lucius, R.; Pufe, T. Antimicrobial peptide rcramp induced glial cell activation through p2y receptor signalling pathways. Mol. Immunol. 2010, 47, 1905–1913. [Google Scholar] [CrossRef]
- Lee, H.S.; Park, C.B.; Kim, J.M.; Jang, S.A.; Park, I.Y.; Kim, M.S.; Cho, J.H.; Kim, S.C. Mechanism of anticancer activity of buforin iib, a histone h2a-derived peptide. Cancer Lett. 2008, 271, 47–55. [Google Scholar] [CrossRef]
- Falagas, M.E.; Kasiakou, S.K. Colistin: The revival of polymyxins for the management of multidrug-resistant gram-negative bacterial infections. Clin. Infect. Dis. 2005, 40, 1333–1341. [Google Scholar] [CrossRef]
- Prenner, E.J.; Lewis, R.N.; McElhaney, R.N. The interaction of the antimicrobial peptide gramicidin s with lipid bilayer model and biological membranes. Biochim. Biophys. Acta 1999, 1462, 201–221. [Google Scholar] [CrossRef]
- Steenbergen, J.N.; Alder, J.; Thorne, G.M.; Tally, F.P. Daptomycin: A lipopeptide antibiotic for the treatment of serious gram-positive infections. J. Antimicrob. Chemother. 2005, 55, 283–288. [Google Scholar] [CrossRef]
- Cheigh, C.I.; Pyun, Y.R. Nisin biosynthesis and its properties. Biotechnol. Lett. 2005, 27, 1641–1648. [Google Scholar] [CrossRef]
- Smith, L.; Lu, S.E. Medical claims and current applications of the potent echinocandin antifungals. Recent Pat. Antiinfect. Drug Discov. 2010, 5, 58–63. [Google Scholar] [CrossRef]
- Joly, V.; Jidar, K.; Tatay, M.; Yeni, P. Enfuvirtide: From basic investigations to current clinical use. Expert Opin. Pharmacother. 2010, 11, 2701–2713. [Google Scholar] [CrossRef]
- McInturff, J.E.; Wang, S.J.; Machleidt, T.; Lin, T.R.; Oren, A.; Hertz, C.J.; Krutzik, S.R.; Hart, S.; Zeh, K.; Anderson, D.H.; et al. Granulysin-derived peptides demonstrate antimicrobial and anti-inflammatory effects against propionibacterium acnes. J. Invest. Dermatol. 2005, 125, 256–263. [Google Scholar]
- Kazemzadeh-Narbat, M.; Kindrachuk, J.; Duan, K.; Jenssen, H.; Hancock, R.E.; Wang, R. Antimicrobial peptides on calcium phosphate-coated titanium for the prevention of implant-associated infections. Biomaterials 2010, 31, 9519–9526. [Google Scholar]
- Papo, N.; Shai, Y. Effect of drastic sequence alteration and d-amino acid incorporation on the membrane binding behavior of lytic peptides. Biochemistry 2004, 43, 6393–6403. [Google Scholar] [CrossRef]
- Svenson, J.; Stensen, W.; Brandsdal, B.O.; Haug, B.E.; Monrad, J.; Svendsen, J.S. Antimicrobial peptides with stability toward tryptic degradation. Biochemistry 2008, 47, 3777–3788. [Google Scholar]
- Scott, R.W.; DeGrado, W.F.; Tew, G.N. De novo designed synthetic mimics of antimicrobial peptides. Curr. Opin. Biotechnol. 2008, 19, 620–627. [Google Scholar] [CrossRef]
- Tew, G.N.; Scott, R.W.; Klein, M.L.; Degrado, W.F. De novo design of antimicrobial polymers, foldamers, and small molecules: From discovery to practical applications. Account. Chem. Res. 2010, 43, 30–39. [Google Scholar] [CrossRef]
- Ostergaard, C.; Sandvang, D.; Frimodt-Moller, N.; Kristensen, H.H. High cerebrospinal fluid (csf) penetration and potent bactericidal activity in csf of nz2114, a novel plectasin variant, during experimental pneumococcal meningitis. Antimicrob. Agents Chemother. 2009, 53, 1581–1585. [Google Scholar] [CrossRef]
- Xiong, Y.Q.; Hady, W.A.; Deslandes, A.; Rey, A.; Fraisse, L.; Kristensen, H.H.; Yeaman, M.R.; Bayer, A.S. Efficacy of nz2114, a novel plectasin-derived cationic antimicrobial peptide antibiotic, in experimental endocarditis due to methicillin-resistant staphylococcus aureus. Antimicrob. Agents Chemother. 2011, 55, 5325–5330. [Google Scholar]
- Ghosh, J.K.; Shaool, D.; Guillaud, P.; Ciceron, L.; Mazier, D.; Kustanovich, I.; Shai, Y.; Mor, A. Selective cytotoxicity of dermaseptin s3 toward intraerythrocytic plasmodium falciparum and the underlying molecular basis. J. Biol. Chem. 1997, 272, 31609–31616. [Google Scholar]
- Porat, Y.; Marynka, K.; Tam, A.; Steinberg, D.; Mor, A. Acyl-substituted dermaseptin s4 derivatives with improved bactericidal properties, including on oral microflora. Antimicrob. Agents Chemother. 2006, 50, 4153–4160. [Google Scholar] [CrossRef]
- Nicolas, P.; El Amri, C. The dermaseptin superfamily: A gene-based combinatorial library of antimicrobial peptides. Biochim. Biophys. Acta 2009, 1788, 1537–1550. [Google Scholar] [CrossRef]
- van der Does, A.M.; Bogaards, S.J.; Ravensbergen, B.; Beekhuizen, H.; van Dissel, J.T.; Nibbering, P.H. Antimicrobial peptide hlf1-11 directs granulocyte-macrophage colony-stimulating factor-driven monocyte differentiation toward macrophages with enhanced recognition and clearance of pathogens. Antimicrob. Agents Chemother. 2010, 54, 811–816. [Google Scholar]
- Steinberg, D.A.; Hurst, M.A.; Fujii, C.A.; Kung, A.H.; Ho, J.F.; Cheng, F.C.; Loury, D.J.; Fiddes, J.C. Protegrin-1: A broad-spectrum, rapidly microbicidal peptide with in vivo activity. Antimicrob. Agents Chemother. 1997, 41, 1738–1742. [Google Scholar]
- Koprivnjak, T.; Peschel, A. Bacterial resistance mechanisms against host defense peptides. Cell Mol. Life Sci. 2011, 68, 2243–2254. [Google Scholar] [CrossRef]
- Cirioni, O.; Silvestri, C.; Ghiselli, R.; Orlando, F.; Riva, A.; Mocchegiani, F.; Chiodi, L.; Castelletti, S.; Gabrielli, E.; Saba, V.; et al. Protective effects of the combination of alpha-helical antimicrobial peptides and rifampicin in three rat models of pseudomonas aeruginosa infection. J. Antimicrob. Chemother. 2008, 62, 1332–1338. [Google Scholar] [CrossRef]
- Pfeufer, N.Y.; Hofmann-Peiker, K.; Muhle, M.; Warnke, P.H.; Weigel, M.C.; Kleine, M. Bioactive coating of titanium surfaces with recombinant human beta-defensin-2 (rhubetad2) may prevent bacterial colonization in orthopaedic surgery. J. Bone Joint Surg. Am. 2011, 93, 840–846. [Google Scholar] [CrossRef]
- Steinstraesser, L.; Trust, G.; Rittig, A.; Hirsch, T.; Kesting, M.R.; Steinau, H.U.; Jacobsen, F. Colistin-loaded silk membranes against wound infection with pseudomonas aeruginosa. Plast. Reconstr. Surg. 2011, 127, 1838–1846. [Google Scholar] [CrossRef]
- Gao, G.; Lange, D.; Hilpert, K.; Kindrachuk, J.; Zou, Y.; Cheng, J.T.; Kazemzadeh-Narbat, M.; Yu, K.; Wang, R.; Straus, S.K.; et al. The biocompatibility and biofilm resistance of implant coatings based on hydrophilic polymer brushes conjugated with antimicrobial peptides. Biomaterials 2011, 32, 3899–3909. [Google Scholar]
- Haynie, D.T.; Zhang, L.; Rudra, J.S.; Zhao, W.; Zhong, Y.; Palath, N. Polypeptide multilayer films. Biomacromolecules 2005, 6, 2895–2913. [Google Scholar] [CrossRef]
- Cole, N.; Hume, E.B.; Vijay, A.K.; Sankaridurg, P.; Kumar, N.; Willcox, M.D. In vivo performance of melimine as an antimicrobial coating for contact lenses in models of clare and clpu. Invest. Ophthalmol. Vis. Sci. 2010, 51, 390–395. [Google Scholar]
- Zhang, L.T.; Yao, Y.M.; Lu, J.Q.; Yan, X.J.; Yu, Y.; Sheng, Z.Y. Recombinant bactericidal/permeability-increasing protein inhibits endotoxin-induced high-mobility group box 1 protein gene expression in sepsis. Shock 2008, 29, 278–284. [Google Scholar] [CrossRef]
- Travis, S.; Yap, L.M.; Hawkey, C.; Warren, B.; Lazarov, M.; Fong, T.; Tesi, R.J. Rdp58 is a novel and potentially effective oral therapy for ulcerative colitis. Inflamm. Bowel. Dis. 2005, 11, 713–719. [Google Scholar]
- Chavakis, T.; Cines, D.B.; Rhee, J.S.; Liang, O.D.; Schubert, U.; Hammes, H.P.; Higazi, A.A.; Nawroth, P.P.; Preissner, K.T.; Bdeir, K. Regulation of neovascularization by human neutrophil peptides (alpha-defensins): A link between inflammation and angiogenesis. FASEB J. 2004, 18, 1306–1308. [Google Scholar]
- Lee, P.H.; Rudisill, J.A.; Lin, K.H.; Zhang, L.; Harris, S.M.; Falla, T.J.; Gallo, R.L. Hb-107, a nonbacteriostatic fragment of the antimicrobial peptide cecropin b, accelerates murine wound repair. Wound Repair Regen. 2004, 12, 351–358. [Google Scholar] [CrossRef]
© 2012 by the authors; licensee MDPI, Basel, Switzerland. This article is an open-access article distributed under the terms and conditions of the Creative Commons Attribution license (http://creativecommons.org/licenses/by/3.0/).
Share and Cite
Brandenburg, L.-O.; Merres, J.; Albrecht, L.-J.; Varoga, D.; Pufe, T. Antimicrobial Peptides: Multifunctional Drugs for Different Applications. Polymers 2012, 4, 539-560. https://doi.org/10.3390/polym4010539
Brandenburg L-O, Merres J, Albrecht L-J, Varoga D, Pufe T. Antimicrobial Peptides: Multifunctional Drugs for Different Applications. Polymers. 2012; 4(1):539-560. https://doi.org/10.3390/polym4010539
Chicago/Turabian StyleBrandenburg, Lars-Ove, Julika Merres, Lea-Jessica Albrecht, Deike Varoga, and Thomas Pufe. 2012. "Antimicrobial Peptides: Multifunctional Drugs for Different Applications" Polymers 4, no. 1: 539-560. https://doi.org/10.3390/polym4010539






